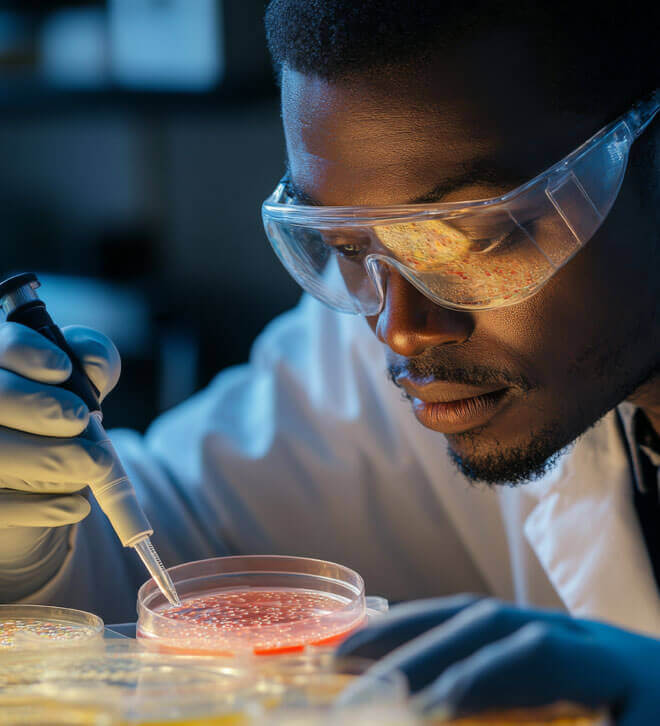
SANBS Purpose Icon

Our Capitals
Our social and relationship capital: Building trust; supporting sustainable development

Our Capitals
Our social and relationship capital: Building trust; supporting sustainable development
Gender Equality
Empowering women and creating equal opportunities

Equitable reward and remuneration (race and gender parity)
SANBS, being a progressive company, is committed to equity, and as such, our leadership recognises the importance of fair remuneration practices that promote both race and gender parity. Policies and practices are reviewed to ensure that all employees receive equitable rewards for their contributions to the company.

Female representation in the workforce is 58.89% (FY24: 59.97%), and women now make up 46% (FY24: 60%) of the Board and 55.55% (FY24: 55.55%) of the Executive Committee. This intentional focus on inclusivity cultivates a culture of equality, empowers female employees to thrive and lead, and creates the foundation for a vibrant workplace that is reflective of the community it serves.
Decent Work and Economic Growth
Promote inclusive and sustainable economic growth, employment and decent work for all



Cultural and leadership initiatives
SANBS is committed to an environment conducive for our employees to thrive and perform. New employees are trained to operate seamlessly and with the appropriate support. See testimonials from three of our employees that demonstrate our commitment to SDG8. Learnerships for people with disabilities – to further embrace our diversity, we currently have 32 (FY24: 19) young People with Disabilities (PWD) on a learnership – see SDG4 for details.
Phlebotomy learnership
The Phlebotomy learnership at SANBS supports South Africa’s National Skills Development Strategy by equipping previously disadvantaged individuals with essential skills. SANBS had 10 phlebotomy students who wrote the Society of Medical Laboratory Technologists of South Africa (SMLTSA) board exam in April 2025 with a 100% pass rate plus 3 distinctions and two students being placed in the top ten performers nationally. Currently SANBS does not have any new students on the learnership. This learnership remains on hold due to regulatory constraints from SANC (South African Nursing Council) and HPCSA. SANBS is actively engaging with both bodies to resolve the impasse and reinstate this critical pipeline programme.

Work experience for qualification opportunities
As part of our community outreach, SANBS has contributed to the development of 28 Technical Vocational Education and Training (TVET) college interns, and 12 Health Professions Council of South Africa (HPCSA) interns, enrolled from January 2022. In addition to ensuring completion of the required work experience for their qualifications, SANBS further supplements their monthly stipend.
We have Medical Technologist Interns, 12 of whom wrote the board exam in March and had a 100% pass rate. They were all permanently appointed at SANBS upon registration with the Health Professionals Council of South Africa (HPCSA) as qualified Medical Technologists. In our current pipeline, 11 Medical Technician students and 31 Technologist Interns are currently in training. They are scheduled to write the board exams in August and September respectively.
Enterprise development and supplier development
Procurement contributed 47.06 points (FY24: 53.67) to SANBS’ B-BBEE score, now compliant on preferential procurement, supplier and enterprise development.
Industry, Innovation and Infrastructure
Investment in research, development and innovation


SANBS is recognised as a centre of excellence with robust intellectual capital, encompassing the expertise of our skilled workforce, including healthcare specialists, supply chain experts, and IT professionals. We are at the forefront of technology in blood transfusion.

In 2021, we established the Research, Advisory and Development (RAD) Academy to empower our people and innovate our processes. It continues to grow from strength to strength.
Increasingly acknowledged for our contributions, SANBS participates in high-profile conferences around the world and is a member of the Blood Genomics Consortium, an initiative aimed at creating a comprehensive and affordable DNA testing for blood group genotyping. This project aims to enhance patient outcomes by reducing alloimmunization rates, with SANBS' diverse donor base providing unique insights that could transform transfusion practices.
Our employees actively engage in local and international research collaborations on topics such as donor health and blood utilisation, resulting in 19 publications during FY25, in peer-reviewed journals and presentations at various academic congresses.
Committed to knowledge sharing across Africa, SANBS collaborated with the Western Cape Blood Service and the African Society for Blood Transfusion to host the first Africa Transfusion Indaba. This event gathered over 36 participants from 12 countries to encourage collaboration and propose a cooperative agenda for blood transfusion education and research.

The theme was "Innovations in Blood Transfusion," featuring contributions from experts such as Dr Caroline Hilton (WCBS), Mr Kobus Strydom (SANBS ICT division), and Mr Rodin Simo (Cameroon Research and Education subcommittee), moderated by Dr. Thabiso Rapodile.
We also welcomed a delegation from Ethiopia for specialised stem cell collection and donor management training, deepening capacity-building efforts across the continent. SANBS embarked on a strategy to innovate with new products and alternate revenue streams. In FY25, SANBS generated alternative revenue in excess of the target.
After the launch of our first smart fridge in 2024, designed to reduce turnaround times for patients needing blood, especially in high-risk areas for mothers during childbirth, we have now added a new 20-unit haemobank smart fridge. This fridge is currently being tested for stable 3G/4G connectivity. If the tests are successful, this technology could be rolled out to more hospitals, further improving our distribution capabilities.
Responsible Consumption and Protection
Climate Action

See natural capital for details relating to SDG 12 and SDG 13.
Peace, Justice and Strong Institutions
Develop effective, accountable and transparent institutions at all levels

Our experienced Board and Exco bring an extensive level of governance expertise to SANBS. SANBS products and services comply with regulatory and national quality standards, ensuring the safety of our blood products and meeting both internal and external customer requirements.

Quality is fundamental to our reputation. We uphold the highest standards through a comprehensive quality framework, achieving a blood safety index of >95% and maintaining a perfect 100% result in our annual SANAS accreditation for the past nine years. Recently, we also received new accreditations from two prestigious organisations, highlighting our achievements in cellular therapies and tissue immunology. See intellectual and manufactured capitals.

